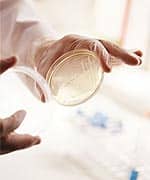

Life Extension Magazine®
For the past 27 years, Life Extension has identified life-saving medications that languished too long in the FDA’s archaic approval process. When effective new drugs are delayed, the inevitable consequence is needless human suffering and death. An equally insidious problem is the chilling effect bureaucratic roadblocks have on the development of better drugs that might actually cure the disease. Just imagine the difficulty of raising the tens of millions of dollars needed to get a new cancer drug into the approval pipeline when prospective investors see the FDA deny a drug with documented efficacy, as was done recently with Provenge®. (Refer to page 7 for the complete story of the FDA’s denial of Provenge®.) Another problem with the FDA’s unpredictable approval pattern is the outrageous cost of the cancer drugs that actually make it to market. Classes of cancer drugs (like anti-angiogenesis agents) that Life Extension long ago advocated are finally approved. The problem is that the out-of-pocket cost of these new drugs can exceed $12,000 per month. The media has reported on heart-wrenching stories of cancer patients who choose to die rather than send their families into bankruptcy from paying these costs. It’s easy to point fingers at drug companies for charging such extortionist prices, but the harsh reality is that getting these medications approved by the FDA is so costly and risky that the high prices can arguably be justified by the hideously inefficient drug approval process that now exists. In this article, we review a few of many drugs that have been shown to be effective against cancer, but are not yet approved by the FDA. While there are dozens of anti-cancer drugs in various stages of the approval process, the sad truth is that thousands of compounds with anti-cancer activity will never be submitted for FDA approval due to lack of patentability, lack of investor funding, or just plain unwillingness to deal with today’s cancer bureaucracy. It has become brutally apparent that the system of drug approval needs a radical overhaul. We have some specific proposals at the end of this eye-opening article. Each day, about 1,500 Americans perish from cancer. Each day, over 3,000 Americans are diagnosed with this dreaded disease.1 While the general population is relatively ignorant about medicine, virtually everyone knows that a cancer diagnosis means exposure to therapies that produce miserable—if not lethal—side effects. The public is also aware that in too many cases, government-approved therapies fail to cure the disease. Promising Ovarian Cancer Drug—Still Not Approved!Back in August 2003, Life Extension wrote about phenoxodiol, a drug that appeared effective in treating ovarian and other cancers. Ovarian cancer kills more than 15,000 women each year in the US alone.1 What makes this type of cancer so insidious is that there are few early warning signs, meaning the disease is usually well advanced when diagnosed. About 80% of ovarian cancer patients present with advanced-stage disease. There is a high rate of relapse after first-line chemotherapy, with less than 10-15% of patients who initially respond to chemotherapy remaining in remission.2 Relapsed cases are often resistant to other chemotherapy agents, leaving them without options for further treatment.3 In May 2003, an announcement emanating from the Yale University School of Medicine stated that phenoxodiol induced 100% cell death in ovarian cancer cell lines, including those cells resistant to chemotherapy drugs such as Taxol® and carboplatin.4 While a number of studies of phenoxodiol are currently underway, it remains unapproved. In early November 2004, the FDA granted fast-track status to phenoxodiol so that Marshall Edwards, Inc., a subsidiary of Novogen, Limited, could become eligible for accelerated marketing approval programs through the FDA.2 The intended use was to benefit ovarian cancer patients who had become resistant or refractory to chemotherapy agents. The FDA acknowledged that these ovarian cancer patients face a life-threatening condition, and that phenoxodiol demonstrates potential to address their unmet need for a medication that can restore chemosensitivity. The Problem with “Accelerated Drug Approval”The FDA usually restricts access to experimental cancer drugs to those patients who have already failed all currently approved conventional therapies. This creates a major obstacle, since new drugs that might cure cancer or induce durable remissions if used in earlier stages may be ineffective in advanced stages of the disease. The reason that it is so difficult to kill advanced-stage, chemotherapy-resistant cancer cells is that these cells have already mutated and acquired multiple survival mechanisms. These advanced-stage cancer cells are thus extremely difficult to eradicate with other therapies. What surprised researchers at Yale is that phenoxodiol killed all ovarian cancer cells (in the laboratory setting), regardless of their resistance to chemotherapy agents.4 Killing cancer cells in a Petri dish is the first step to identifying potential anti-cancer drugs. The greater challenge is getting these same drugs to function effectively in the human body. By restricting clinical testing of phenoxodiol only to advanced cancer patients (who have already failed anti-cancer treatments such as surgery, radiation therapy, and/or one or more chemotherapy agents), a bureaucratic hurdle is erected that precludes optimal evaluation of the drug, i.e., testing it in early-stage cancer, when drug resistance is most likely minimal or absent. While the FDA seems to have acknowledged the potential of phenoxodiol as early as the year 2004, and despite the fact that clinical trials reveal no significant adverse side effects, ovarian cancer patients are still waiting for the approval of this drug.5 Since phenoxodiol is only being tested in advanced-stage cancer patients, scientists may never know if it would be effective in early-stage cases. Phenoxodiol Has Multiple Mechanisms of ActionPhenoxodiol was discovered when scientists were studying the anti-cancer properties of soy genistein plant extracts. The scientists used data collected from this research to synthesize (and patent) phenoxodiol, which is a genistein analog. There are both oral and intravenously administered versions of phenoxodiol. Phenoxodiol functions via several unique mechanisms to induce cancer cells to undergo programmed cell death (apoptosis). Normal cells undergo apoptosis in a controlled manner so they can be replaced with healthier-functioning cells. Cancer cells, on the other hand, have undergone genetic mutations that prevent them from self-destructing. The ultimate goal of a cancer therapy is to induce malignant cells to undergo apoptosis, instead of indefinitely proliferating out of control. Phenoxodiol works via several mechanisms, including altering a signal pathway in cancerous cells that prevents them from undergoing apoptosis (programmed cell death). These findings indicate that the drug could be successful at treating many types of cancer. The study in which researchers at Yale showed how phenoxodiol kills cancer cells was published in the May 1, 2003, issue of Oncogene, but advanced-stage cancer patients still have to apply to enter a clinical trial to have any chance of accessing it, and of course entry slots into such clinical trials are extremely limited.4
Phenoxodiol Studies in Ovarian CancerPreliminary results of a clinical trial conducted at the Cleveland Clinic found that more than half of the 10 patients tested using phenoxodiol showed some response.6 Each of these patients had different types of advanced cancer that did not respond to chemotherapy. The researchers also tested phenoxodiol in mice and found that when dosed at 20 mg/kg every day for six days there was a three-fold reduction in tumor mass compared with a control group. No side effects were noted. In a May 2006 report published in the International Journal of Cancer, phenoxodiol was acknowledged by researchers in Australia as an agent that directly inhibits the proliferation of tumor cells by inducing apoptosis and disrupting the process of cell division. In addition, their in vivo angiogensis study demonstrated that phenoxodiol may also have the ability to combat the other process that drives tumor growth, namely, angiogenesis, the stimulation of the vasculature that provides the tumor with its blood supply.7 Another study published in October 2006 by Australian researchers in Cancer Chemotherapy and Pharmacology used a dose-escalating study on a small number of human cancer patients to find the maximum tolerated dose and toxicity of phenoxodiol.5 They found that toxicity was minimal, and a maximum tolerated dose was never reached. Despite the fact that most of the 21 patients they treated had advanced cancers with progressive disease, they noted that at least one patient responded to treatment with stabilization of disease status for six months before further progression. As noted earlier, cancer patients with advanced-stage disease are unlikely to respond well to any therapy. In the case of ovarian cancer, the high mortality rate arises not only because of difficulties with detecting the disease in its early stages when symptoms are not apparent, but also due to the widespread development of chemoresistance.3 One of the major areas of study involving phenoxodiol concerns its potential as a chemosensitizing agent in the treatment of ovarian cancer. In January 2005, Oncology Research reported that in laboratory studies conducted at Yale, phenoxodiol increases the effectiveness of docetaxel (Taxotere®) by at least 100 times.8 In other words, when the researchers measured the effect on human ovarian cancer cells previously found to be resistant to docetaxel, the synergistic effect of phenoxodiol combined with docetaxel allowed for the use of only 1/100th of the amount of docetaxel, which proved to be as effective as the standard dose of docetaxel alone. This potential for the reduction of dosage in standard chemotherapy agents could result in a dramatically improved quality of life for patients undergoing chemotherapy due to the reduction in chemotherapy’s toxic side effects. Co-administration of phenoxodiol with standard chemotherapy agents also allows for the administration of both agents at lower doses, while retaining significant anti-tumor activity compared with mono-therapy, according to researchers at Yale who reported on a new chemotherapy study in the April 2007 issue of Cancer Biology and Therapy.9 Their report states that they have previously shown that phenoxodiol is able to sensitize epithelial ovarian cells to pacitaxel, carboplatin, gemcitabine, and docetaxel. In previously conducted in vitro studies and in their current in vivo studies in mice, it was demonstrated that in over half of the cell lines tested (which were previously determined to be resistant to a newer chemo drug called topotecan), pretreatment with phenoxodiol demonstrated a clear therapeutic advantage. A report on phenoxodiol research conducted at New Zealand’s leading medical research facility was released on May 1, 2007. The research included laboratory studies and Phase II clinical trials on human subjects with resistant ovarian cancer.10 Professor Michael Berridge, PhD, calls phenoxodiol a novel drug and cites its unique mechanism of action, which is not exhibited by other anti-cancer drugs currently in use. Phenoxodiol is described as an agent that works by targeting a specific protein that occurs only on cancer cells and inducing their destruction. Since this particular protein does not occur on healthy cells, they suffer no damage from phenoxodiol. Dr. Berridge notes that phenoxodiol is the first compound to operate via this signal disruption pathway. This class of drugs will be called “Multiple Signal Transduction Inhibitors,” or “MSTRs.” While over 1,000 women perish each month from ovarian cancer, the drug remains bogged down in the lengthy FDA approval process. A multi-national Phase III clinical trial is finally underway at 60 sites in the US, Europe, and Australia. Called the OVArian TUmor REsponse study, or OVATURE, it is recruiting recurrent or persistent advanced patients with ovarian, fallopian tube, or primary peritoneal cancers.11 Preliminary results from the trial are expected within 18 months—meaning 22,000 American women and countless other women throughout the world might needlessly die from ovarian cancer who should have been allowed to access phenoxodiol before they developed advanced disease.
Phenoxodiol Delays Progression of Prostate CancerPhenoxodiol is also being tested for the treatment of prostate cancer, beginning with hormone-refractory (advanced) prostate cancer patients. It is hoped that when phenoxodiol and other drugs in its class are eventually developed, tested, and approved, they will also be useful in the treatment of early-stage prostate cancer. In November 2005, it was reported that in Phase IB/IIA clinical trials, phenoxodiol was demonstrated to significantly delay tumor progression in late-stage, hormone-refractory prostate cancer patients.12 The anti-tumor effect was dose dependent with the two highest dosages, 200 and 400 mg, given three times a day for 21 days with the next 7 days without treatment, proving to be the most effective. The study conducted in Australia was scheduled to end after 24 weeks, but due to the unexpected extended survival and lack of toxicity (which might have limited the use of the drug), the trial was extended to 90 weeks and beyond. The lead investigator noted that phenoxodiol provided a significant anti-tumor effect in patients whose disease has progressed to the point where it is normally unresponsive to treatment, with a few patients experiencing reductions in PSA of 50% or greater from baseline and many patients experiencing dramatic extension of PSA doubling times. American oncologists who specialize in the treatment of prostate cancer were very excited by these findings and the potential for phenoxodiol to impact the treatment of both early- and late-stage prostate cancer patients, and very interested in studying the ability of phenoxodiol to restore sensitivity to standard chemotherapy agents in end-stage prostate cancer patients.13 The potential of phenoxodiol in the treatment of hormone-refractory prostate cancer that is resistant to chemotherapy resulted in the FDA’s approval of fast-track status for this use in early 2005, but prostate cancer patients note that there has been a significant delay in the investigations needed to win approval. The Novogen Phase I trial being conducted on solid tumors may potentially enroll prostate cancer patients, but as of this date, it appears that no other significant trials are underway.13 Press releases have indicated that due to financial constraints the company that holds the patent rights to phenoxodiol has had to defer further studies relating to prostate cancer patients and to restrict its clinical trials to ovarian cancer. Given the apparent efficacy of phenoxodiol in prostate cancer, such obstruction to further study and/or access of phenoxodiol to patients with life-threatening diseases should be considered criminal. The fault lies not with the company, but with the FDA. Phenoxodiol and MelanomaAustralian researchers are also targeting human melanoma cells using phenoxodiol to induce apoptosis. This work will try to pinpoint the mechanisms by which specific proteins of the apoptosis cascade are affected. In January 2007, Yale researchers reported in the Journal of Translational Medicine that pretreatment with phenoxodiol can sensitize melanoma cells to carboplatin, a currently available chemotherapy agent. This research has promising implications for use in the treatment of metastatic melanoma, and most probably for any malignancy where carboplatin has shown activity, such as ovarian, breast, prostate, testicular, lung, and other cancers.14 Phenoxodiol and Squamous Cell CarcinomaOral phenoxodiol is being tested at Yale in Phase IB in patients with squamous cell carcinomas of the cervix, vagina, or vulva, and in adenocarcinoma of the cervix.15 The study will assess phenoxodiol as monotherapy in these patients, and examine its safety and tolerability. The intravenous form of phenoxodiol continues to be used in Phase IB/IIA ovarian and other gynecological cancer clinical trials at Yale as a chemosensitizing agent in combination with various chemotherapy regimens. The patients under study have recurrent disease resistant to platinum or taxane-based chemotherapy.15
| ||||||
How Many Lives Have Been Needlessly Ended?Phenoxodiol’s minimal toxicity, demonstrated anti-tumor activity, high specificity for tumor cells, ability to enhance the effectiveness of therapy with various chemotherapy agents, and efficacy in reversing chemoresistance, would seem to meet the “chicken soup test,” thus conferring a significant probability of benefit without much potential for harm. Every month, more than 1,000 women succumb to ovarian cancer. Advanced prostate cancer patients who have exhausted the conventional therapies presently available to them are left with little hope for survival and a dismal quality of life. Phenoxodiol was discovered in April 2002. If phenoxodiol turns out to be even partially effective, the delay in getting it into the hands of the cancer patients who so desperately need it will have meant countless sacrifices in quality of life. The number of needless, untimely deaths caused by this delay could number over one million. Why do we have a problem with earlier access to such promising therapies? This is disgraceful. Promising Bone Cancer Drug Still Not Approved!The day May 9, 2007 has been called “Black Wednesday” by the Wall Street Journal based on the FDA’s refusal that day to approve two highly promising cancer drugs.16 One of these drugs is JunovanTM, which was developed to improve outcomes for patients with high-grade non-metastatic osteosarcoma, the most common form of bone cancer.17 The FDA’s Oncologic Drugs Advisory Committee (ODAC) recommended against approval of Junovan™ for advanced-stage patients. The final decision on Junovan™ may come in late August 2007.18 Although many cancer patients suffer from bone metastasis secondary to other types of cancer elsewhere in their bodies (such as in the breast, prostate, or lung), primary bone cancer is relatively rare. Only 400 to 1,000 new cases of the form of bone cancer known as osteo-sarcoma are diagnosed annually in the United States; a similar incidence of osteosarcoma exists in Europe. Osteosarcoma accounts for about 3-5% of childhood cancers and has an overall five-year survival rate of only 60-65%.17,19 How Junovan™ WorksStandard cancer treatments include surgery, chemotherapy, and radiation therapy. Junovan™ is a “biologic therapy” or “immunotherapy.”19-21 Biologic therapies or immunotherapies use the patient’s own immune system to fight cancer by boosting, directing, or restoring the body’s natural defenses against cancer.20 Junovan™ is a synthetic derivative of a naturally occurring component of bacterial cell walls called MTP-PE (muramyl tripeptide phosphatidylethanolamine).17 It is an immune system stimulator designed to destroy cancer cells by activating macrophages present in the patient’s tissues.21 Macrophages are a type of white blood cell. Macrophages release substances that stimulate the immune system, and they also have the ability to take in and destroy foreign substances such as bacteria and tumor cells.22 Junovan™ is administered by intravenous infusion.17 The Statistics Don’t Tell the StoryTo understand the impact of the potential refusal of the FDA to approve Junovan™, it’s necessary to understand the impact of osteosarcoma on those patients who are diagnosed with this insidious type of cancer. Because osteosarcoma usually develops from osteoblasts (bone-forming cells), it affects mainly children and young adults between the ages of 10 and 25, whose long bones undergo a period of rapid growth during adolescence. In children and adolescents, tumors appear most often in the bones around the knee.19 In Phase III clinical trials with non-metastatic, localized osteosarcoma, Junovan™ demonstrated a clear reduction in the risk of recurrence and death, yet the FDA committee hung its hat on a statistical difference of 1% (94% certainty versus 95% certainty) in the probability of efficacy to justify a 12-2 “no” vote.23 Not a single comment was made about the immunologic clinical data supporting the efficacy of this agent.16 Statistics were the main consideration by the FDA panel in making its decision to recommend against approval of Junovan™.
In October 2006, IDM Pharma, Inc., the pharmaceutical company now completing the development of Junovan™, submitted a New Drug Application to the FDA, seeking approval for its use in patients with newly diagnosed resectable high-grade osteosarcoma following surgical resection (surgical removal of the cancer in the affected bone) in combination with multiple agent chemotherapy. The Phase III study, which provided the evidence of Junovan’s efficacy and safety, was supported by 17 Phase I and Phase II studies that preceded it, and was conducted by a different pharmaceutical company than the one that began its development.23 Studies that date back to the late 1980s, conclude that the systemic administration of MTP-PE rendered the blood monocytes of cancer patients toxic to cancer cells.24 Thus began a long and arduous study of the possibilities of using MTP-PE as an agent in an immunologic strategy to activate the patient’s own immune system to marshal its defenses against cancer. When the FDA application was submitted, there was optimism that Junovan™ would bring new hope of survival for osteosarcoma. When the “no” vote was issued by the FDA committee, it was again emphasized that there have been no new treatments for this type of cancer in over twenty years, and that there is a significant unmet need for safe and effective treatments to help these young cancer patients.21 The principal investigator in the Phase III clinical trial cited in the New Drug Application was Dr. Paul Meyers, Vice Chair of Pediatrics at Memorial Sloan-Kettering in New York City.25 It was the largest Phase III trial studying osteosarcoma to ever be published, reporting data on 678 newly diagnosed patients who fit the criteria of the study, i.e., non-metastatic cancers that were of a size and in a location where they could be removed by surgery and that were staged as high-grade rather than low-grade.21 Dr. Meyers was quoted as saying that despite advances in surgical and chemotherapeutic approaches, the outcome can be very poor for a substantial proportion of patients and Junovan™, if available to patients, will provide physicians with a new tool that has significant potential to improve outcomes and most importantly, survival.21 The Phase III trial on which the FDA application was based demonstrated a relative reduction in risk of recurrence of 25% and a relative reduction in the risk of death of 30%. These findings were considered by the researchers to be clinically meaningful in a pediatric population where the longer the survival, the greater the chance that the patient is cured of cancer.26 When osteosarcoma recurs, it is usually within two to three years after the completion of treatment. Later recurrence, though possible, is rare.20 A typical standard course of treatment for the average patient takes place over a period of 29 weeks or longer, depending on how quickly the patient responds or recovers from surgery or other therapy.27 In a typical treatment regimen, surgery is usually preceded by 10 weeks of chemotherapy and followed by 18 more weeks of chemotherapy.27 Other commonly used chemotherapy agents include doxorubicin, cisplatin, ifosfamide, and etoposide.28 The median follow up time in the latest Phase III study was almost five years so that any recurrence that was likely to happen could be included in the statistics.21 Despite this very thorough and convincing evidence of Junovan™’s efficacy with minimal adverse events, the FDA sent IDM Pharma and its team of researchers back to the drawing board, apparently to achieve another 1% probability of efficacy, without regard to the impact on the children and families struggling with the human side of suffering.
Beyond the Statistics: The Human Side of SufferingIn the Phase III study of Junovan™, adverse events associated with its use were generally mild to moderate, including flu-like symptoms such as chills, fever, nausea, vomiting, muscle pain, headache, fast heart rate, hypotension or hypertension, fatigue, and shortness of breath. These discomforts are consistent with the activation of monocytes and macrophages by Junovan™, since flu-like symptoms are known to follow cytokine release.21 These minimal side effects are probably unavoidable, since they are thought to be associated with the biological activity that causes Junovan™ to work. Since high-dose, multiple-drug chemotherapy was used in the Phase III trial along with Junovan™, some patients did experience severe adverse events, but they were those typically associated with the chemotherapy, as opposed to the Junovan™ administration.17 For those who are diagnosed with the stage of cancer that Junovan™ is designed to treat, non-metastatic Stage II cancers, the prognosis is relatively good. With standard therapy combining surgery and chemotherapy both before and after the surgery, patients without detectable metastases have about a 60-65% survival rate. This survival rate has remained stable since the mid-1980s because the standard of treatment has remained static, with no new innovations to improve the odds.21 The Phase III clinical study of Junovan™ is supported by 17 Phase I and Phase II clinical studies in which an additional 248 patients received at least one dose of Junovan™. The survival data show that with the addition of Junovan™, the survival rate at six years jumps from 66% (with a range of 59% to 73%) to 77% (with a range of 72% to 83%), yet the FDA’s committee failed to recommend approval of Junovan™. The FDA is charged with the duty of protecting the public from the hazards of potentially dangerous or damaging foods and drugs. Protecting the public without regard to any reasonable degree of common sense at the cost of their very lives is not, and should not, be included in the job description of the FDA! Promising Melanoma and Leukemia Drug Still Not Approved!Metastatic melanoma and chronic lymphocytic leukemia (CLL) often prove fatal. A unique drug called Genasense® has been developed by a small pharmaceutical company to combat these and other cancers. The FDA has refused to approve it, ignoring compelling evidence of the drug’s efficacy.30 Genasense® is an “antisense” drug. Antisense drugs work by targeting one or more proteins in cancer cells responsible for cellular proliferation, drug resistance, or other mechanisms that have given cancer cells a survival advantage.29 Genasense®, for example, targets bcl-2, a protein that functions to protect cancer cells from cell death (apoptosis). Genasense® blocks the bcl-2 protein, removing this cancer survival mechanism, therefore causing death of the cancer cell. There is very little potential for side effects because normal cells don’t exhibit the large quantity of bcl-2 that is characteristic of cancer cells.31
Administered intravenously, Genasense® is designed to be used synergistically with a wide range of anti-cancer therapies, including chemotherapy, radiation, monoclonal antibodies, and immunotherapy agents.31 The goal of anti-cancer therapy is to introduce toxic substances that induce apoptosis in cancer cells, while suppressing substances like bcl-2 that prevent cancer cells from dying.29 The bcl-2 protein has the ability to protect cancer cells from signals sent by a variety of chemotherapy agents that promote apoptosis. Therefore, co-administration of Genasense® with other agents and therapies is a strategy designed to enhance, rather than compete with, other forms of anti-cancer therapy. A host of commonly used chemotherapy drugs and other agents have already been tested in clinical trials in combination with Genasense®.31 Genasense® ResearchGenasense® research dates back to 1997, when the Journal of Pharmacology and Experimental Therapeutics reported on a study in mice that looked at its effect on the bcl-2 protein.32 Genta, the pharmaceutical company that developed Genasense®, has plans to conduct clinical trials on cancers such as melanoma, multiple myeloma, acute myeloid leukemia, chronic lymphocytic leukemia, prostate cancer, colon cancer, and lung cancer.31 Because of the potential to increase the cancer-killing activity of many standard anti-cancer therapies, and because it has potential to work in so many different types of cancer, Genasense® holds promise for a diverse group of cancer patients, some of whom have exhausted standard chemotherapy options.31 Take for example the description of the effect of Genasense® on a patient who enrolled in a clinical trial described in the October 1999 issue of Seminars in Hematology. Preclinical toxicity studies had already established that G3139, as Genasense® was called at that time, was well tolerated with minimal toxicity. But most interesting was that one human being suffering from Stage IVB follicular lymphoma achieved a complete clinical and radiologic response that had already lasted more than two years at the time of publication.33 Subsequent studies have confirmed the activity of Genasense®. In the February 2007 issue of the Journal of Clinical Oncology, a study conducted at 100 centers around the world and involving patients with advanced chronic lymphocytic leukemia (CLL) was reported. These were patients who had relapsed on prior chemotherapy regimens. The study compared Genasense® in combination with fludarabine and cyclophosphamide (two established drugs used in CLL) with a control arm in which the two chemotherapy agents were used without Genasense®. The findings showed that 17% of patients in the Genasense® plus chemo arm achieved a complete or partial response, as opposed to 7% of patients who were treated only with chemotherapy.34,35 Furthermore, the durability of the remissions in the patients who received Genasense® was significantly longer. The duration of the remission exceeded 36 months on average in the Genasense® group, as opposed to 22 months in the group receiving chemotherapy alone. An impressive 70% of the patients who received Genasense® in combination therapy were alive at three years, versus only 38% for the patients who did not receive Genasense® combination therapy.34,35 This is convincing evidence, but apparently not sufficiently convincing for the FDA panel. David and Goliath and the FDA’s ErrorThe FDA’s decision on Genasense® seems to be the ultimate in bureaucratic incompetence and an unbelievable injustice to the cancer patients who are waiting for the marketing of this promising drug. The researchers had randomized, controlled clinical trials demonstrating that Genasense® confers a benefit to patients in the clinical setting, and both primary and secondary endpoints were achieved in Phase III clinical trials. Accordingly, on March 1, 2006, Genta submitted a New Drug Application requesting approval of Genasense® with fludarabine and cyclophosphamide for the treatment of patients with relapsed or refractory CLL.36 In September, 2006, the FDA’s committee voted 7 to 3 against the recommendation for approval of Genasense®. None of the members of the committee were CLL experts, and there are allegations of conflict of interest in two of the voting members.30 In a follow-up meeting, Genta presented information regarding the clinical benefit of Genasense®, enlisting CLL experts to help plead their case. Still, the FDA insisted that the long-lasting disappearance of disease demonstrated by the clinical trials was a “theoretical construct” and not grounds for approval.30 The FDA’s committee finally acknowledged the complete responses in the CLL patients, but was still unmoved despite the unanimous appeal of the leukemia experts requesting approval. The FDA subsequently rejected Genasense® after suggesting that the small, financially struggling company just give the drug away under their expanded access program. Genta responded that they could not afford to give it away, and that the FDA non-approval was therefore a denial of patient access to Genasense®. Ironically, the FDA’s mantra is that the best avenue to patient access to new drugs is through approval, yet they refused to approve Genasense® despite compelling evidence of its efficacy and benefit to patients.30 Genta filed an appeal of the FDA’s decision in April 2007, but they were forced to reduce staff so they could stay in business long enough to appeal the FDA’s decision. Approval for use of Genasense® for treatment of melanoma was similarly denied. This was the result of an apparent mathematical error on the part of the FDA in analyzing the data. Genta is filing a complaint under the Federal Data Quality Act to correct the record, but meanwhile, melanoma patients have the same access to Genasense® as leukemia patients—NONE, except through clinical trials, which are continuing despite all adversity.30 This is the classic story of the small struggling company up against an unreasonable and often insensitive government bureaucracy. Caught in the middle are millions of patients and multi-millions of their loved ones. There is a saying that “he who saves one life saves the world.” Apparently, the FDA’s committee does not have this as part of its philosophy. This “process” needs to be drastically altered, and now, before more lives are prematurely ended. Promising Kidney Cancer DrugRenal cell carcinoma (RCC), or carcinoma of the kidney, is a difficult form of cancer to treat. Approximately 25% of the estimated 51,000 diagnosed this year with kidney cancer will present with advanced disease—defined by locally invasive disease to distant metastatic disease at the time of diagnosis.1,37 The prognosis is generally dismal, and only 20% of such patients survive five years. Estimated deaths in the USA in 2007 from RCC approach 13,000.37 The incidence of this form of cancer is highest in people between the ages of 50 and 70, with more men affected than women. Enter Torisel™ (temsirolimus), being developed by Wyeth Pharma-ceuticals for use in patients with advanced RCC. Recognizing an international need for new therapies to prolong the lives of kidney cancer patients, Wyeth submitted both a New Drug Application to the FDA, and a marketing authorization application to the European Medicines Agency in October 2006.37 Torisel™ was previously granted FDA fast-track designation in July 2004 and was granted the agency’s “orphan drug” designation in December 2004. Torisel™ also received Orphan Medicinal Product designation for the treatment of RCC in the European Union in March 2006, prior to the application date.37 Evidence of EfficacyTorisel™ inhibits a protein that regulates cancer cell growth and proliferation and cell survival. It was the first drug of its kind to be submitted for FDA approval, a landmark drug which uses a very different strategy to target cancer. Torisel™ works by fooling cancer cells into thinking they’re starving. The tumor population, believing that it lacks sufficient nutrients for growth, stops dividing.38 Phase III clinical trials involving 626 patients indicated that the drug conferred improved survival in terminal RCC patients, with an increased survival of 3.6 months, or nearly 50%. Patients randomized to Torisel™ survived 10.9 months, compared with 7.3 months for patients who received interferon-alpha alone. Interferon-alpha is a traditional treatment for kidney cancer.39 In this study, adverse effects included weakness, loss of energy, and anemia. Those patients randomized to treatment arms lacking interferon had fewer adverse effects than the patients who received Torisel™ alone, so at least some of the adverse effects might be attributable to the interferon-alpha.39 Given these Phase III clinical trial results, there was optimism that approval by the FDA would quickly be forthcoming. Like the other drugs profiled in this article, cancer patients had to be in an advanced stage of the disease to participate in the clinical trials. The fact that these drugs are showing clear survival benefits when cancers are at such a difficult-to-treat juncture implies that these drugs could be more effective if allowed to be used in early-stage cancer patients. The FDA, however, ignores this basic understanding of biologic systems. Any disorder—be it cancer, diabetes, heart disease, Alzheimer’s, obesity, and even global warming—is always more successfully treated when therapeutic measures are initiated early, in contrast to waiting until the end-stages of the condition. It’s just plain common sense. The Death TollIn May 2007, it was announced that although Wyeth Pharma-ceuticals expected FDA approval as early as April 2007, it was not to be. In fact, the FDA extended its review of Torisel™ until July 2007 to examine additional data on tumor evaluation. Wyeth’s presentation on the efficacy of the new drug concentrated on overall survival, while the FDA decided that the efficacy of the drug should also be measured by its effect on tumor progression.40 Certainly, the patients themselves would side with the pharmaceutical company, and not the FDA. Since many renal cell carcinoma patients die within three months of diagnosis, Torisel™ brings a ray of hope in a sea of hopelessness for prolonging patients’ time on this earth. For a time, the FDA seemed to turn a blind eye to these patients while insisting on still more data. Their delay denied RCC patients a few additional months of life that might have resulted in their being around— to see their children graduate from college, get married, celebrate anniversaries with beloved spouses, or do anything they always wanted to do before they died. But just as this article was going to press, the FDA approved Torisel™ for use in patients with advanced kidney cancer. The drug is expected to be available to patients in 2007.41 The hopes and dreams of patients and their loved ones, as well as the very loss of life, often seem secondary to the bureau’s mission to protect the public at all costs. But today, at least patients with advanced RCC have a hope for prolonged survival that they didn’t have yesterday. Our upset remains with the thousands of kidney cancer victims and the similar scenarios involving patients with other types of cancer who needlessly or prematurely died and continue to die while the FDA delayed, and continues to delay, approving drugs that deal with drastic illnesses. | |||||
The FDA’s Lethal ImpedimentNot only do FDA policies delay life-saving drugs from being approved, but they often keep effective medications off the market forever! Take the case of Geron, a pharmaceutical company that is aggressively researching and developing a telomerase vaccine that would “teach” the patient’s own immune system to attack cancer cells while sparing other cells.42 If a small company like Geron were to run out of money before it could conclude the expensive clinical trials required for FDA approval, its vaccine research program could come to a grinding halt. The FDA does have a “compassionate use” exemption that allows cancer patients access to experimental therapies.43 The problem is that the FDA mandates that these cancer patients first fail so-called “proven” therapies. When cancer cells are exposed to “proven” therapies like radiation or chemotherapy, they mutate in a way that causes them to become super-resistant to future therapies. The patient’s healthy cells (including dendritic cells of the immune system) are often seriously impaired when exposed to these “proven” treatments, thus making therapies like Geron’s telomerase vaccine less likely to be effective. Contrast this with a free choice policy of giving dying cancer patients the chance to try Geron’s new vaccine immediately. Under this system, it could be possible to determine whether the vaccine worked within months, as opposed to the multi-year period currently mandated by the FDA. If it worked, then millions of cancer patients’ lives would be saved. If the vaccine failed, then these terminally ill cancer patients will have died as they would have anyway, willingly accepting the risks involved, and sacrificing their lives in the hope of saving the lives of those who come after them. Getting the Best Therapies to Cancer Patients Now!
There are effective therapies and cancer detection methods approved by governments in countries other than the USA. Medical articles published in peer-reviewed journals read by physicians around the globe attest to the efficacy of such treatments and methodologies. A risk-free example of what Europeans have that Americans don’t is a diagnostic procedure called Combidex®. This procedure can detect lymph node metastases as small as 5 mm with a 95% level of accuracy.44 Combidex® has the potential to revolutionize the practice of oncology, yet the FDA has failed to recognize its potential and grant approval in the US. Combidex® involves the use of MRI (magnetic resonance imaging) in conjunction with a novel contrast agent—nanoparticles of iron. The very same iron nanoparticles are used to correct the anemia commonly occurring in patients on renal dialysis. Over 4,000 patients have been studied in the Netherlands with Combidex®. But Americans and Canadians wishing to have this study to most accurately document the extent of their cancer and to then choose treatment strategies that will optimize the chance of success have to travel to the Netherlands. The FDA rejected the approval of Combidex®. Apparently, it would rather have patients go through surgery and/or radiation and fail either or both therapies due to lack of proper staging of the disease. Given this, it is no wonder that more patients are not cured of cancer, and that the cost of healthcare is so outrageous. We need to bring proven diagnostic tools like Combidex® to patients in the USA who agonize over whether or not their cancer is systemic, and who have to decide whether to undergo local or regional therapies like surgery and/or radiation, when in reality their cancer may already be outside of the anatomic areas that can be cured by such therapies. Photodynamic therapy (PDT) is approved for treating skin lesions, non-small cell lung cancer, and cancerous conditions of the esophagus, but its potential in treating a broader range of cancers has been largely overlooked.45 Abraxane® is now approved for use in breast cancer, but it is still not approved for anything else, despite evidence that it almost certainly will be effective against prostate and other cancers that have shown sensitivity to chemotherapy with taxanes such as Taxol® or Taxotere®.46 Abraxane® is another example of nanotechnology, as is Combidex®. In fact, Abraxane® is simply a nano-particle of Taxol® that is bound to albumin. Abraxane® is nab-paclitaxel, which simply stated is nanoparticle, albumin-bound Taxol®. Such nanoparticle technology allows for better penetration of the anti-cancer agent into the tumor’s vascular plexus. Additionally, tumor cells have albumin receptors that appear to attract the nab-paclitaxel (Abraxane®). Abraxane® has been approved by the FDA for treatment of metastatic breast cancer only. The FDA has required the manufacturers of Abraxane® to do further clinical trials to prove efficacy in women with breast cancer who are to receive taxane chemotherapy in the absence of metastatic disease. Imagine this mentality—the drug works in metastatic disease, but now the company should spend more millions of dollars to show that it works in less extensive disease. Can we afford this blatant waste of life and healthcare dollars? Xinlay™ (atrasentan) has been shown to double the time to progression of disease in prostate cancer patients, compared with placebo, but the FDA has still not approved it.47,48 We need to expand patient access to the countless promising drugs and technologies that have been determined to be safe, but have not yet been approved, or that are destined to meet their demise without ever receiving the touch of the FDA’s golden scepter. An Interim Proposal for FDA ReformCancer patients should have access to drugs and technologies that have shown minimal toxicity, but that have shown efficacy based on peer-reviewed literature and formal presentations at recognized medical conferences. Such drugs and/or technologies could be granted a “semi-approval status” by the FDA with the implication that at some future date they could be granted full FDA approval. The conditions for availability of such drugs and technologies would involve: 1. Patient access to drugs with evidence of significant activity and safety. 2. Pharmaceutical company ability to charge for agents without jeopardizing economic solvency, while agreeing to cost reductions of agents resulting from semi-approval status. 3. Ongoing collection of complete and accurate data by designated physicians that is submitted for review. 4. Physician reimbursement for services in delivering therapies. 5. Legal counsel preparing documents to eliminate risk of litigious actions. Patients wanting access to agents must assume risks and waive access to liability. 6. Creating task forces consisting of scientists, consumers, and other relevant individuals involved in a quarterly review process of clinical data. We believe that access to state-of-the-art medicine is the birthright of all individuals. Included in that birthright is the option to use whatever alternative medicine or innovative medical procedure or pharmaceutical agent seems prudent, as it becomes available, without suppression by a politicized and bureaucratic governmental agency. There is a revolution brewing, and FDA reform is the target. Every individual patient and all of those who are stakeholders—and that’s all of us—can be part of the solution, rather than passively accepting the status quo and remaining part of the problem. A government responsive to the needs of the people can’t help but recognize the legions of cancer patients and their loved ones who are taking to the streets in support of the approval of Provenge®, carrying signs and demanding that their voices be heard.49,50 Other campaigns—such as the “Raise A Voice” movement being conducted by prostate cancer patients who are running out of time—are waging war on their cancer by confronting the myopic agency that prevents them from gaining access to the drugs and procedures that can prolong the length and improve the quality of their lives.51 We are all a part of this struggle. This is our government, and these are our lives and the lives of our loved ones that are being jeopardized by an agency that seems increasingly inept and ripe for reform. We need to act now, before our very lives ebb away, as do those of thousands of cancer patients who are dying every day in the FDA’s waiting room. What YOU can do! On page 13 of this issue of Life Extension magazine, there is a description of the legislative action you can take now to stop these needless cancer deaths. The Life Extension Foundation has set up an easy-to-use website that lets you type in your zip code and then easily email your Representative and two Senators a letter urging them to support legislation that would provide seriously ill patients with quicker access to potential life-saving medications. We ask every Life Extension supporter to spend only a few minutes to let their members of Congress know how critical it is to tear down the bureaucratic walls that are causing tens of thousands of Americans to die needlessly each year. To log on to this special legislative website immediately, go to: www.lifeextension.com/lac If you have any questions or wish to discuss any aspect of this article, please call one of our Health Advisors at 1-800 226-2370.
| |||||||||||||||||||||||||||||||
| References | |||||||||||||||||||||||||||||||
| 1. Available at: www.cancer.org/docroot/stt/stt_0.asp. Accessed June 11, 2007. 2. Available at: www.docguide.com/news/content.nsf/news. Accessed June 11, 2007. 3. Mor G, Fu HH, Alvero AB. Phenoxodiol, a novel approach for the treatment of ovarian cancer. Curr Opin/Investig Drugs. 2006 Jun;7(6):542-8. 4. Kamsteeg M, Rutherford T, Sapi E, et al. Phenoxodiol--an isoflavone analog—induced apoptosis in chemoresistant ovarian cancer cells. Oncogene. 2003 May 1;22(17):2611-20. 5. de Souza PL, Liauw W, Links M, Pirabhahar S, Kelly G, Howes LG. Phase I and pharmacokinetic study of weekly NV06 (Phenoxodiol), a novel isoflav-3-ene, in patients with advanced cancer. Cancer Chemother & Pharmacol. 2006 Oct;58(4):427-33. 6. Available at: www.marshalledwardsinc.com/index04.cfm?section=04&status=1&id=124. Accessed June 11, 2007. 7. Gamble JR, Xia P, Hahn CN, et al. Phenoxodiol, an experimental anticancer drug, shows potent antiangiogenic properties in addition to its antitumor effects. Int J Cancer. 2006 May 15;118(10):2412-20. 8. Available at: www.marshalledwardsinc.com/index04.cfm?section=04&status=1&id=165.Accessed June 11, 2007. 9. Alvero AB, Brown D, Montagna M, Matthews M, Mor G. Phenoxodiol-Topotecan Co-Administration Exhibit Significant Anti-Tumor Activity Without Major Adverse Side Effects. Cancer Biol Ther. 2007 Apr. 19;6(4). [Epub ahead of print] 10. Available at: www.marshalledwardsinc.com/index04.cfm?section=04&status=1&id=211.Accessed June 11, 2007. 11. Available at: http://clinicaltrials.gov/ct/show/NCT00382811?order=1. Accessed June 11, 2007. 12. Available at: www.newswise.com/articles/view/516230/. Accessed June 11, 2007. 13. Available at: www.hrpca.org/phenoxodiol.htm. Accessed June 11, 2007. 14. Kluger HM, McCarthy MM, Alvero AB, et al. The X-linked inhibition of apoptosis protein (XIAP) is up-regulated in metastatic melanoma, and XIAP cleavage by Phenoxodiol is associated with Carboplatin sensitization. J Transl Med. 2007 Jan 26;5:6. 15. Available at: www.marshalledwardsinc.com/index.cfm?section=03&subsec=0316#10. Accessed June 11, 2007. 16. Available at: http://online.wsj.com/article/SB117911315709601659.html?mod=article-outset-box. Accessed June 11, 2007. 17. Available at: http://ir.idm-biotech.com/phoenix.zhtml?c=193146&p=irol-newsArticle&ID=759764&highlight=. Accessed June 11, 2007. 18. Available at: http://www.pharmalive.com/News/index.cfm%3Farticleid%3D440765. Accessed June 11, 2007. 19. Available at: http://cancer.iu.edu/osteosarcoma/index.php. Accessed June 11, 2007. 20. Available at: www.nci.nih.gov/cancertopics/pdq/treatment/osteosarcoma/patient/allpages/print. Accessed June 11, 2007. 21. Available at: http://www.drugs.com/nda/junovan_061026.html.Accessed June 11, 2007. 22. Available at: http://en.wikipedia.org/wiki/Macrophage. Accessed June 11, 2007. 23. Available at: www.drugs.com/nda/junovan_070509.html. Accessed June 11, 2007. 24. Kleinerman ES, Murray JL, Snyder JS, Cunningham JE, Fidler IJ. Activation of tumoricidal properties in monocytes from cancer patients following intravenous administration of liposomes containing muramyl tripeptide phosphatidylethanolamine. Cancer Res. 1989 Aug 15;49(16):4665-70. 25. Available at: http://cancer.iu.edu/osteosarcoma/patients/stories/cindi/php. Accessed June 11, 2007. 26. Available at: www.drugs.com/nda/junovan_070403.html. Accessed June 11, 2007. 27. Available at: http://cancer.iu.edu/osteosarcoma/patients/timeline/index.php. Accessed June 11, 2007. 28. Available at: http://cancer.iu.edu/osteosarcoma/patients/intreatment/chemotherapy/. Accessed June 11, 2007. 29. Strum SB, Pogliano D. A Primer on Prostate Cancer, The Empowered Patient’s Guide. 2nd ed. Hollywood, FL: The Life Extension Foundation; 2005. 30. Available at: http://online.wsj.com/article/SB117824324837591781.html. Accessed May 22, 2007. 31. Available at: http://www.genta.com/genta/Products/genasense.html. Accessed May 25, 2007. 32. Raynaud FI, Orr RM, Goddard PM, et al. Pharmocokinetics of G3139, a phosphorothioate oligodeoxyneucleotide antisense to bcl-2, after intravenous administration or continuous subcutaneous infusion to mice. J Pharmacol Exp Ther. 1997 Apr;281(1):420-7. 33. Cotter, FE. Antisense therapy of hematologic malignancies. Semin Hematol. Oct;36(4 Suppl 6):9-14. 34. Available at: http://genta.com/Genta/InvestorRelation/2007/press_20070214.html. Accessed May 31, 2007. 35. O’Brien S, Moore JO, Boyd TE, et al. Randomized Phase III Trial of Fludarabine Plus Cyclophosphamide With or Without Oblimersen Sodium (Bcl-2 antisense) in Patients With Relapsed or Refractory Chronic Lymphocytic Leukemia. J Clin Oncol. 2007; 0:JCO. 2006.07.1191v1. 36. Available at: www.genta.com/Genta/InvestorRelation/2006/press_20060301.html. Accessed June 4, 2007. 37. Available at: http://www.drugs.com/nda/torisel_061096.html. Accessed May 30, 2007. 38. Available at: http://www.thejournalnews.com/apps/pbcs.dll/article?AID=/20070325/BUSINESS01/703250307/1066&template=printart. Accessed June 12, 2007. 40. Available at: http://news.morningstar com/news/ printNews.asp?id=/News/DJ/200705161321DOWJONESDJONLINE000845_univ.xml. Accessed June 12. 2007. 41. Available at: http://www.wyeth.com/news?nav=display&navTo=/wyeth_html/home/news/pressreleases/2007/1180576865144.html. Accessed June 12, 2007. 42. Available at: http://www.geron.com/showpage.asp?code=prodcatv. Accessed June 12. 2007. 43. Available at: www.curetoday.com/backissues/v3n3/departments/specialreport/. Accessed June 12, 2007. 44. Available at: http://www.fda.gov/ohrms/dockets/AC/05/slides/2005-4095S1_01_05-AdvMag-Barentsz.ppt#755,1. Accessed June 12, 2007. 45. Available at: http://www.cancer.org/docroot/CRI/content/CRI_2_6x_photodynamic_therapy.asp?sitearea=. Accessed June 12, 2007. 46. Available at: http://www.nytimes.com/2005/01/08/business/08drug.html?ex=1262926800&en=850b1ce92db6387b&ei=5088&partner=rssnyt. Accessed June 12, 2007. 47. Available at: http://psa-rising.com/med/research/atrasentan-Xinlay-asco05.htm. Accessed June 12, 2007. 48. Available at: http://www.hrpca.org/atrasentan.htm. Accessed June 12, 2007. 49. Available at: http://www.nytimes.com/2007/06/04/health/04drug.html?ex=1181793600&en=8aadd4d94116b406&ei= 5070. Accessed June 12, 2007. 50. Available at: http://psa-rising.com/blog/index.php/2007/06/02/washington-dc-june- 4th-prostate-cancer-walk. Accessed June 12, 2007. 51. Available at: http://psa-rising.com/blog/index.php/2007/06/. Accessed June 12, 2007. 52. Small EJ, Schellhammer PF, Higano CS, et al. Placebo-controlled phase III trial of immunologic therapy with sipuleucel-T (APC8015) in patients with metastatic, asymptomatic hormone refractory prostate cancer. J Clin Oncol. 2006 Jul 1;24(19):3089-94. 53. Available at: http://professional. cancerconsultants.com/oncology_main_news.aspx?id=38681. Accessed July 5, 2007. 54. Beinart G, Rini BI, Weinberg V, Small EJ. Antigen-presenting cells 8015 (Provenge) in patients with androgen-dependent, biochemically relapsed prostate cancer. Clin Prostate Cancer. 2005 Jun 4;4(1):55-60. 55. Available at: http://www.aacrmeetingabstracts.org/cgi/content/abstract/2004/1/1028-a?maxtoshow=&HITS=10&hits=10&RESULTFORMAT= 56. Available at: http://www.aacrmeeting abstracts.org/cgi/content/abstract/2006/2/A27?maxtoshow=&HITS=10&hits=10&RESULTFORMAT=1&author1=morre&andorexacttitle= 57. Available at: http://www.marshalledwardsinc.com/index04.cfm?section=04&status=1&id=163. Accessed July 5, 2007. 58. Romet-Lemonne JL, Mills B, Fridman WH, Munsel M. Prospectively planned analysis of data from a phase III study of liposomal muramyltripeptide 59. Bedikian AY, Millward M, Pehamberger H, et al. Bcl-2 antisense (oblimersen sodium) plus dacarbazine in patients with advanced melanoma: the 60. Nelson JB, Carducci MA, Zonnenberg B, et al. The endothelin-A receptor antagonist atrasentan improves time to clinical progression in hormone 61. Available at: http://www.asco.org/portal/site/ASCO/menuitem.34d60f5624ba07fd506fe310ee37a01d?vgnextoid= 62. Gradishar WJ, Tjulandin S, Davidson N, et al. Phase III trial of nanoparticle albumin-bound paclitaxel compared with polyethylated castor oil-based paclitaxel in women with breast cancer. J Clin Oncol. 2005 Nov 1;23(31):7794-803. 63. Harisinghani MG, Barentsz J, Hahn PF, et al. Noninvasive detection of clinicallyoccult lymph-node metastases in prostatecancer. N Engl J Med. 2003 Jun19;348(25):2491-9.
|